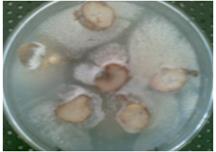
4

1Padmashree Institute of Management, Sciences, Faculty of Biotechnology, Kommaghatta, Bangalore 560060, India, ²Rishi Foundation # 2365, 19th Cross Banashankari 2nd Stage, Bangalore 560070, India
Email: kashphytochem@yahoo.com
Received: 08 Jun 2015 Revised and Accepted: 08 Aug 2015
ABSTRACT
Objective: Coleus forskohlii is the only known source of Forskolin-a labdanediterpene and a highly valuable phytochemical. Coleus forskohlii has been listed as endangered plant; therefore, efforts have been made to find novel sources of Forskolin production.
Methods: Endophytic fungi were isolated from Coleus forskohlii tissue and screened for Forskolin production by using thin layer chromatography (TLC) method. Further, 16 different elicitation media combinations were used to enhance the Forskolin content.
Results: In this study, out of 38 strains of endophytic fungi from Coleus forskohlii only 2 strains EF1 and EF2 were found to synthesize Forskolin in mycelium, whereas EF2 was found to release the Forskolin into the broth. Further, EF2 was identified as Rhizactonia bataticola accession no. NFCCI 2028. Further, T2S1 media showed dramatic effects on enhanced Forskolin production in mycelium. However, there was a significant increase about four folds in broth which corresponded to 0.5 mg compared to T1S1 media where it was 0.09 mg.
Conclusion: The present study suggests that the Forskolin producing Rhizactonia bataticola and T2S1 media can serve as potential materials for large scale enhancement of Forskolin production.
Keywords: Coleus forskohlii, Forskolin, Endophytic fungi, Rhizactoniabotaticola, TLC, Elicitor.
© 2016 The Authors. Published by Innovare Academic Sciences Pvt Ltd. This is an open access article under the CC BY license (http://creativecommons.org/licenses/by/4.0/)
INTRODUCTION
Coleus forskohlii or Indian Coleus is a tropical perennial member of a mint (Lamiaceae) family and grows in the subtropical temperate climates of Thailand, Nepal, Srilanka, and India. Plant grows approximately 1-2 feet high and its striking leaves are shiny green and teardrop shaped. Depending on the amount of shade, leaf color varies accordingly. Pale purple or blue flowers form a cluster which branches off a single stem. The root stock is thick, fibrous, golden brown and radially spreading.
Presently, the Coleus plant is extensively cultivated in southern India and is used in Indian folk medicines as a traditional digestive remedy. It has been used in ayurvedic medicine for many years. The power herb has a pharmacologically active compound in it called Forskolin [1, 2] (fig. 1). The roots are harvested when their color is brightest, which is an indication that the Forskolin is available at its most concentration. The Forskolin produced by Coleus forskohlii is interesting from a scientific and medicinal standpoint as it dilates the blood vessels and helps to lower blood pressure, hence, considered to be a good heart tonic. Forskolin is traditionally used in the treatment of heart diseases, respiratory disorder, insomnia, convulsions, asthama, bronchitis, burning sensation, intestinal disorders, abdominal colic, constipation, epilepsy and angima [3].
The methanolic extract of Coleus forskohlii root tubers was shown to reduce blood pressure and had positive inotropic activity in animal models [4]. Forskolin is an adenylate cyclase stimulant that increases intracellular cyclic adenosine monophosphate (c-AMP) [5, 6]. Anti-inflammatory activity [7] and Anti-allergic activity such as inhibition of histamine release [8] has also been shown. Forskolin not only enhances burning fat but also inhibits accumulation and storage of fats [9]. Forskolin may also be able to regulate insulin secretion [10]. Recent findings on the pharmacological activity of Forskolin have been comprehensively reviewed [11-13].
Forskolin is a labdane diterpene that has been shown to interact with different membrane proteins including adenylyl cyclase, the gluscose transporter, the voltage-gated potassium channel and ligand-gated ion channels [14]. The ability of Forskolin to stimulate adenylyl cyclase in intact cells in the absence of hormonal agonists has been exploited by many laboratories for investigation of the role of cyclic Adenosine monophosphate (AMP) in various physiological functions, with the exception of one, all of them are stimulated by Forskolin [15-17].
Since Coleus forskohlii is the only known source of Forskolin. It has been heavily collected from its natural habitats and therefore listed as endangered [18]. Although the current requirements for Forskolin are being met through large scale cultivation of this plant, but the herbal industry is still facing problems because; 1) Plant has to be grown till the Forskolin content in its roots reaches to maximal levels and therefore is time consuming. 2) Cultivated plant material shows variations in Forskolin content which ranges from 0.1% to 0.44% [19].
Scientists have found various other methods like Suspension cell cultures [20, 21] and hairy root cultures [22, 23] of Coleus forskohlii to synthesize the Forskolin naturally and enhance its content. Plant growth regulators like α-naphthaleneacetic acid (NAA), if used in root culture media has also been shown to enhance the Forskolin content [24].
Due to the huge demand, current industrial production of Forskolin by Coleus forskohlii cannot meets the requirement of the global market. The growing demand for Forskolin as an important therapeutic agent and less productivity rate has led to the evaluation of different biotechnological tools for increased production of Forskolin. Therefore scientists around the world have taken up a new approach for industrial production of Forskolin. One such novel method is isolation of Forskolin producing endophytic fungi. So far many secondary metabolite producing endophytic fungi have been isolated by scientists across the globe [25]. Our study shows the production of Forskolin from endophytic fungi isolated from Coleus forskohlii. In addition, various strategies were used to enhance the Forskolin production in endophytic fungi by using combinations of different kinds of carbon sources, elicitors and precursors in the growth media and the yield of Forskolin in broth was enhanced four folds.
MATERIALS AND METHODS
Collection of plant material for isolation of endophytic fungi
Coleus forskohlii cuttings were collected from herbal garden maintained by Rishi Herbal Technologies Pvt. Ltd. Bangalore, India. Stems, leaves, and roots were cut with the help of the sterile scalpel and were placed in sterile plastic bags to store the material at 4 °C until isolation procedure was started.

Fig. 1: Forskolin molecular structure
Isolation of endophytic fungi from Coleus forskohlii
For isolation of endophytic fungi from Coleus forskohlii, leaves, 3 cm thick segments of root and stem were washed with liquid detergent for 10 min to remove the surface contaminants and dirt, followed by through rinsing with tap water. Then surface sterilization was carried with 2% sodium hypochlorite solution for 7 min, followed by rinsing with sterile distilled water. These segments were finally sterilized by submerging them into 75% ethanol for 5 min inside the sterile hood [26]. After 5 min segments were removed and alcohol was allowed to evaporate, which was followed by removing the outer bark of both stem and root with sterile sharp blade. Leaves and inner tissue of stem and root were cut into 1 cm thick segments and placed on aqueous agar media (distilled water+2% agar) supplemented with 10µg/ml streptomycin as an antibiotic to suppress bacterial growth in petri plates[26]. The inoculated plates were incubated at 28±2 °C until growth was initiated. After the incubation period of 10-15 d, emerging hyphae from the tissues of leaves, stems and roots were observed. Emerging hyphae were transferred to fresh Sabauraud agar medium (SDA) containing peptone (1%) dextrose (4 %) and agar (1.5%) and further incubated at 28±2 °C [26]. Afterwards fungi were periodically sub-cultured till pure cultures were obtained. To check for surface contaminating fungi, same procedure but without surface sterilization was used as a negative control.
Maintenance of endophytic fungi liquid cultures
Endophytic fungi obtained were screened for the presence of Forskolin produced by host plant Coleus forskohlii. Each fungal strain isolated in this study was grown in liquid fungal growth media containing peptone 1% and dextrose 4%. Agar plugs containing mycelium were used as inoculum. The conical flasks with growth media and fungus were grown at 28±2 °C under shaking conditions. The flasks were kept for 7 d on shaker incubator (Orbital Shaking Incubator, Biocare Technologies, and India) with 150 rpm at 25 °C. After every 24 h, two flasks of isolated endophytic fungi were separately sacrificed and harvested for down streaming and Forskolin detection.
Extraction, identification and authentication of Forskolin from endophytic fungi
For detection of Forskolin, the incubated cultures were filtered through whatmann filter paper. The pellet of endophytic fungal isolates was separately re-suspended in deionized water and homogenized, cell free broth was lyophilized. Both homogenized pellet and lyophilized broth of fungal isolates was extracted three times with an equal volume of ethyl-acetate. Organic solvent was later removed by rotary evaporation (SHI-209, Shivam instrument, India). All the prepared extracts were subjected to thin layer chromatography (TLC) in comparison with standard Forskolin for detection and quantification.
Identification of Forskolin producing strain of endophytic fungi
Out of 38 strains of endophytic fungi isolated from Coleus forskohlii leaves, roots and stems, two strains were found to be positive for Forskolin production. The fungal strain which showed the presence of Forskolin in both extracts of broth as well as mycelium, was further sent for identification to National fungal culture collection of India (NFCCI), Agharkar Research Institute, Pune, India. In addition, the fungal strain was independently stained with lacto-phenol blue, to observe under the microscope.
Elicitation of endophytic fungus for enhanced Forskolin production
One strain of endophytic fungi, which were identified as fungal strain accession no. NFCCI 2028 was grown separately in 16 different types of media combinations which were used to enhance the Forskolin production (table 1). Fungal strain was cultured separately in 100 ml of each media/broth combination in conical flasks. Cultures were kept on a rotary shaker incubator for 10 d at 150 rpm. After 10 d Forskolin was extracted from broth and mycelium as explained above.
Table 1: Various media compositions used to grow Rhizactonia bataticola
Media code |
Concentration of plant extract (%) |
Media composition |
P1D1 |
2% aqueous extract of coleus plant leaves |
Peptone 10 g, Dextrose 40g/l |
T1D1 |
Tryptone 10g, Dextrose 40g/l |
|
P2D1 |
Peptone 15g, Dextrose 40g/l |
|
T2D1 |
Tryptone 15g, Dextrose 40g/l |
|
P1D2 |
Peptone 10g, Dextrose 35g/l |
|
T1D2 |
Tryptone 10g, Dextrose 35g/l |
|
P2D2 |
Peptone 15 g, Dextrose 35g/l |
|
T2D2 |
Tryptone 15g, Dextrose 35g/l |
|
P1S1 |
Peptone 10 g, Sucrose 40g/l |
|
T1S1 |
Tryptone 10g, Sucrose 40g/l |
|
P2S1 |
Peptone 15g, Sucrose 40g/l |
|
T2S1 |
Tryptone 15 g, Sucrose 40g/l |
|
P1S2 |
Peptone 10g, Sucrose 35g/l |
|
T2S2 |
Tryptone 10g, Sucrose 35g/l |
|
P2S2 |
Peptone 15g, Sucrose 35g/l |
|
T1S2 |
Tryptone 15g, Sucrose 35g/l |
Detection and verification of endophytic Forskolin by thin layer chromatography (TLC) method
Fungal strain accession no. NFCCI 2028 was grown in 16 different media combinations for 10 d and the Forskolin was extracted from broth and mycelia after two days interval as mentioned above. TLC method described by[27], with some modifications was carried out with ethyl-acetate extracts of broth and mycelium of endophytic fungi along with authentic Forskolin standard (98%) which was procured from Rishi herbal technologies Pvt. Ltd. Bangalore. The extracts of all the samples and standard Forskolin (1 mgml-1) were dissolved in methanol and 50 µl of each was spotted on TLC aluminum silica plates (60F254, 20 x 20 cm) (EMERCK Ltd.) almost 2 cm away from base of the sheet, all spots were 1 cm apart from each other. Mobile phase used in saturation chamber was Hexane and Ethyl-acetate in the ratio of 6:4 (v/v). Samples were made to run till 95 mm on TLC sheet in the chamber. TLC plate was removed from the chamber and air dried followed by spraying with Anisaldehyde-sulfuric acid spraying reagent (0.5 ml of Anisaldehyde mixed with 10 ml of 98% v/v glacial acetic acid and followed by adding 85 ml of methanol and 5 ml of concentrated Sulfuric acid and heated for 3-4 min at 140 °C). After spraying with reagent, the TLC plate was incubated in the hot air oven (BTI-29, Bio technics, India) at 105 °C for 5 min. The Forskolin appeared as a compact dark purple/violet spot on TLC plate.
Quantification of endophytic Forskolin by spectrophotometric method
The purple/violet spots of the sample (corresponding to standard Forskolin) and standard Forskolin which were developed on TLC sheet after spraying with Anisaldehyde sulfuric acid reagent were carefully scraped out and then separately dissolved in 1 ml methanol and filtered with 0.2 µm filter. The filtrate was made up to 3 ml with methanol and absorbance was recorded using a spectrophotometer (Spectronics 20D+, Milton Roy company, India) at 545 nm using a suitable blank. The mean absorbance value of the amounts studied in triplicates was plotted against concentration of Forskolin to get a calibration curve. Unknown sample absorbance was recorded and plotted to derive the concentration of Forskolin using the standard curve.
Calibration curve
Different stock solutions of standard Forskolin (98%) with concentration 0.2, 0.4, 0.6, 0.8 and 1 mgml-1 were prepared in methanol. From each concentration, 50 µl was spotted on a TLC plate.
Sample preparation
The ethyl acetate extract of broth and mycelia was dried and equal amounts were dissolved in 3 ml of methanol. 50 µl of the sample solution was used for spotting on a TLC plate.
RESULTS
Isolation of endophytic fungi from Coleus forskohlii
Coleus forskohlii was selected as a source plant for isolating the Forskolin producing endophytic fungi. Several parts of Coleus forskohlii like leaves, roots and stems were used for isolation. At 28±2 °C growths was found to be initiated (fig. 2). The fungal hyphae were sub-cultured on mycological agar medium to obtain pure cultures. Finally, 38 pure endophytic fungi were isolated 7 from leaves, 13 from stem and 18 from roots. To establish the de-novo production of Forskolin by the isolated fungi, the growing mycelium was serially transferred several times to fresh mycological agar [26].
Fig. 2: Endophytic fungi grown from root samples of Coleus forskohlii
Screening of endophytic fungi for detection of Forskolin
All the 38 fungal strains were then screened for Forskolin synthesis. TLC detection method showed that out of 38 fungal strains isolated, only 2 fungal strains EF1 and EF2 from root showed positive results of Forskolin synthesis. Among these 2 positive strains, EF1 strain showed Forskolin synthesis in mycelium but not in broth, whereas interestingly, the other strain EF2 displayed Forskolin synthesis in mycelium as well as in broth. The Rf value of Forskolin was 0.27±0.02. The capability of Forskolin synthesis in EF1 was completely lost after repeated sub-culturing. Further, EF2 was stained with lacto-phenol blue and its hyphae and sporangium were observed under the microscope (fig. 3A, B, C). Further, the EF2 strain was identified as Rhizactonia bataticola accession no. NFCCI 2028.
Elicitation of endophytic fungus for enhanced Forskolin production
The endophytic fungi EF2 which was identified as Rhizactonia bataticola accession no. NFCCI 2028, is the first Forskolin producing endophytic fungi and very stable. Rhizactonia bataticola was promising as it had the capability to release the synthesized Forskolin into the broth from 4-7th day of its growth. 16 different types of media combinations were used to enhance the Forskolin production (table 1). The results show that the media coded as T2S1 consisting of Tryptone 15 g/l, sucrose 40g/l and 2% aqueous extract of coleus forskolii leaves dramatically enhanced the growth rate (table 2) and highest Forskolin production 0.5 mg in broth, which was about four folds more compared to T1S1 (Tryptone 10 g/l, sucrose 40g/l and 2% aqueous extract of coleus forskolii leaves) where it was just 0.09 mg (fig. 4A, B). However, Rhizactonia bataticola grown in all the other 14 media compositions showed slow growth rate and significantly low Forskolin content in mycelium and broth (table 2). These results suggest that tryptone when present in optimum quantity in combination with sucrose plays an important role in fungal growth and therefore enhanced Forskolin synthesis.
The graph in fig. 5 clearly shows that Forskolin was produced by Rhizactonia bataticola in both mycelium and broth when grown in all combinations of media. But, interestingly, Rhizactonia bataticola grown in media coded as T2S1 showed maximum biomass and hence maximum amount of Forskolin production in broth. Therefore, suggesting that T2S1 could be used for large scale production of Forskolin in future.

Fig. 3: Rhizactonia bataticola A) Pure culture B, C) microscopic view (hy-Hyphae, sp-Sporangium)
Table 2: Rhizactonia bataticola extract weight in different media compositions
Culture code |
Broth volume (ml) |
Mycelium weight (g) |
Extract weight (mg) |
|
Mycelium (mg) |
Broth (mg) |
|||
1.1-P1D1 |
100 |
1.21±0.1 |
0.03±0.0001 |
0.03±0.0002 |
2.1-T1D1 |
1.62±0.2 |
0.05±0.0001 |
0.01±0.0001 |
|
3.1-P2D1 |
1.23±0.1 |
0.03±0.0002 |
0.01±0.0001 |
|
4.1-T2D1 |
1.35±0.1 |
0.03±0.0001 |
0.009±0.00003 |
|
5.1-P1D2 |
1.31±0.1 |
0.06±0.0002 |
0.04±0.0002 |
|
6.1-T1D2 |
1.73±0.3 |
0.07±0.0002 |
0.04±0.0002 |
|
7.1-P2D2 |
1.39±0.1 |
0.05±0.0001 |
0.03±0.0001 |
|
8.1-T2D2 |
1.66±0.3 |
0.05±0.0001 |
0.07±0.0002 |
|
9.1-P1S1 |
1.2±0.1 |
0.02±0.0001 |
0.03±0.0001 |
|
10.1-T1S1 |
2.32±0.2 |
0.3±0.001 |
0.09±0.0002 |
|
11.1-P2S1 |
1.37±0.1 |
0.02±0.0001 |
0.06±0.0001 |
|
12.1-T2S1 |
2.44±0.1 |
0.3±0.002 |
0.5±0.0001 |
|
13.1-P1S2 |
1.25±0.1 |
0.01±0.0001 |
0.008±0.00002 |
|
14.1-T1S2 |
1.05±0.05 |
0.03±0.0001 |
0.04±0.0001 |
|
15.1-P2S2 |
1.29±0.1 |
0.02±0.0001 |
0.06±0.0002 |
|
16.1-T2S2 |
1.55±0.3 |
0.04±0.0002 |
0.03±0.0002 |
|
Data represents mean ±SE from six biological replicates. Data was analyzed by Student’s t-Test

Fig. 4: A) TLC plate showing presence of Forskolin in broth and mycelium (My) of Rhizactonia bataticolain comparison with Standard Forskolin (Std.) B) Rhizactonia bataticolaculture when grown in T2S1 liquid media

Fig. 5: Comparison between Forskolin content in mycelium (Mat) and broth of Rhizactonia bataticola, grown in different media compositions. Data represents mean±SE from six biological replicates
Role of tryptone in Forskolin synthesis
Elicitors like salicylic acid, methyl-Jasmonic acid etc have been used for secondary metabolite synthesis [28]. Rhizactonia bataticola accession no. NFCCI 2028 was grown in tryptone rich, T2S1 media, in which the highest amount of Forskolin was produced and interestingly released into broth. The results shown in fig. 4 and fig. 5 suggest that tryptone is playing a very important role in dramatically enhancing the Forskolin synthesis. Forskolin is synthesized by three different pathways i) Non-Mevalonate Pathway ii) Acetate Mevalonate pathway (MAV pathway) and, iii) Indole diterpene Alkaloid biosynthesis pathway. All the three biosynthetic pathways have an amino acid, tryptophane as a precursor in common, which eventually leads to the synthesis of Forskolin (fig. 6). The tryptone used in T2S1 media is very rich in tryptophane, therefore, our results suggest that tryptone provided in the T2S1 media may have been taken up and utilized for Forskolin biosynthesis by Rhizactonia bataticola, resulting in enhanced levels of Forskolin in broth.

Fig. 6: Schematic showing the role of Tryptone in Forskolin synthesis pathway
DISCUSSION
Forskolin (fig. 1) is naturally synthesized in roots of Coleus forskohlii plant, which is an herb. Forskolin extracted from roots of this plant has been used as a drug from many years. The only known source of Forskolin, Coleus forskohlii has been threatened due to destructive collection from its natural habitats [18]. Although the current requirements for Forskolin are being met through large scale cultivation of this plant, but depending upon the conditions in which the plant was cultivated, the Forskolin content changes from about 0.1% to 0.44% [19]. Therefore, supply of Forskolin produced does not meet the current demand. Hence, an alternative method of Forskolin production, which is efficient, cost effective and less time consuming, needs to be found, so that the sufficient quantity of Forskolin is generated. It is only possible if micro-organisms are used for production of Forskolin. As micro-organisms are simpler than plants, easy to modify, could be utilized for bioreactor studies and have short life cycle about 10 d, whereas, it takes around 6 mo for the Coleus forskohlii plant to grow and develop proper roots and precise Forskolin content.
A new area of research and development has been initiated with recent discoveries of endophytic fungi and their ability to produce important phytochemicals. Many endophytic fungi have been isolated which have been shown to produce important phytochemicals native to the plant like Taxol [29-31], Camptothecin [28, 32, 33], Podophyllotoxin [34, 35], Vinblastine and Vincristine [36, 37] etc.
However, Rhizactonia bataticola is the first Forskolin producing endophytic fungi which is stable. Rhizactonia bataticola not only synthesized Forskolin but interestingly was capable of releasing it into the broth. This quality of endophytic fungi is unique and important in terms of bio-processing and down streaming as the process of chemical extraction of Forskolin becomes easy. However, the loss of Forskolin producing capability of EF1 could be attributed to the lack of molecular cues in the media, which are normally received from the native plant.
Elicitors like salicylic acid, methyl-Jasmonic acid etc have been used for secondary metabolite synthesis [28]. However, the elicitors used in this study were tryptone, peptone, sucrose, dextrose and 2% coleus leaf extract. Among them, tryptone and sucrose in presence of 2% coleus leaf extract proved to be optimum elicitors for Rhizactonia bataticola, resulting in the enhanced production about 0.5 mg of Forskolin in broth. The screening method employed in this study was TLC and spectrophotometry based, which indeed was simple, precise and easy. The Rf value of Forskolin in this study was 0.27±0.02, which was also shown in previous study [38]. Furthermore, Rhizactonia bataticola and the media used may have the potential to enhance the Forskolin production in large scale.
CONCLUSION
Forskolin is naturally synthesized in roots of Coleus forskohlii plant-the only known source, which has been threatened due to destructive collection from its natural habitats. Hence, an alternative method of Forskolin production, which is efficient, cost effective and less time consuming, needed to be found, so that the sufficient quantity of Forskolin is generated. It is only possible if micro-organisms are used for production of Forskolin. As micro-organisms are simpler than plants, easy to modify, could be utilized for bioreactor studies and have short life cycle about 10 d, whereas, it takes around 6 mo for the Coleus forskohlii plant to grow and develop proper roots and Forskolin production. Rhizactonia-bataticola accession no. NFCCI 2028, Forskolin producing endophytic fungus was isolated for the first time from Coleus forskohlii roots. The results suggest that using tryptone and sucrose in presence of 2% coleus plant extract as elicitors could be used as a potential alternative strategy to enhance the Forskolin levels in broth. Further, investigation to find out the important molecules involved in Forskolin biosynthesis pathway need to be carried out.
ACKNOWLEDGEMENT
The authors highly acknowledge the internal funding support of Rishi Foundation. We also thank Padmashree Institute of Management and Sciences, Bangalore, India for providing the resources and infrastructure, which enabled us to do this study.
CONFLICT OF INTERESTS
Declared None
REFERENCES